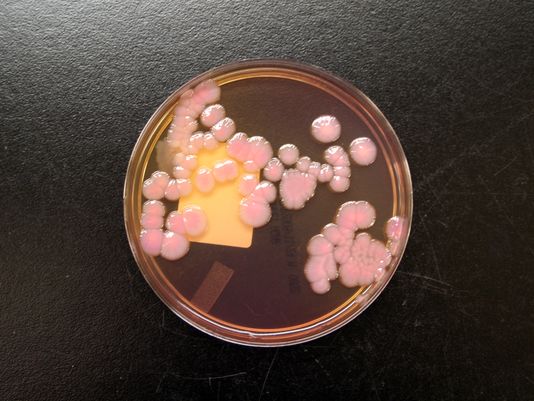

La lista ahora incluye infecciones por Enterobacteriaceae (resistente a carbapenem), Neisseria gonorrhoeae (multiresistente) y Clostridium difficile (multiresistente).
A lab specimen of antibiotic-resistant Enterobacter cloacae, which belongs to a family of infectious bacteria, known as CRE, that defies even drugs of last resort.
The overuse of antibiotics has caused three kinds of bacteria — one that causes life-threatening diarrhea, one that causes bloodstream infections and one that transmits sexually — to become urgent threats to human health in the United States, federal health officials say in a landmark report out Monday.
The report from the federal Centers for Disease Control and Prevention (CDC) is the first to categorize the threats posed by such germs in order of immediate importance, from «urgent,» to «serious,» to «concerning.» It is also the first to quantify the toll of such so-called superbugs, saying they cause at least 2 million infections and 23,000 deaths each year.
«It’s not too late» for the nation to respond, rein in the infections and keep antibiotics working by reserving them for when they are truly needed, but several steps must be taken right away, CDC director Tom Frieden said Monday. «If we are not careful and we don’t take urgent action, the medicine cabinet may be empty for patients with life-threatening infections in the coming months and years.»
On the urgent list:
• Carbapenem-resistant Enterobacteriaceae (CRE), bacteria that cause 9,000 infections in hospitals and other health-care facilities each year. The CDC says nearly half of hospital patients who get CRE bloodstream infections die from them. It’s a «nightmare infection,» Frieden says.
• Drug-resistant gonorrhea, a sexually transmitted infection that now resists several antibiotics that used to cure it. CDC estimates 30% of the 800,000 U.S. cases each year fit that description.
• Clostridium difficile, a serious diarrhea-causing infection that is not highly resistant to antibiotics but does thrive when antibiotics are over-used. The bacteria cause 250,000 infections and 14,000 deaths each year.
The list of serious infections includes 11 kinds of drug-resistant bacteria and one fungus (Candida); the list of infections that cause concern includes three additional kinds of bacteria. The bugs were categorized based on their health impact, economic impact, how common they are, how common they could become, how easily they spread, how well they still respond to medication and how difficult they are to prevent.
The gist of the problem is that the more often these bugs encounter antibiotics, the more likely they are to adapt in ways that make the drugs less effective — and, eventually, useless.
With the new numbers and urgent tone, «the CDC is signaling that this is a major, major public health threat,» says Ramanan Laxminarayan, director of the Center for Disease Dynamics, Economics & Policy in Washington. It puts the threat in terms the public and lawmakers can grasp and «is long overdue,» he says.
CDC says there are several ways to get a handle on the problem, but the most important is to «change the way antibiotics are used,» by cutting unneeded use in humans and animals and using the right antibiotics in the right way when they are needed.
Other steps include preventing infections in the first place with tools such as vaccines, safe food handling, hand-washing and infection-control plans in hospitals and other health care settings; better tracking of resistant infections and developing new antibiotics and tests for drug resistance.
Those are all important steps, but even more should be done, says Helen Boucher, an infectious disease specialist at Tufts Medical Center in Boston, and a board member of the Infectious Diseases Society of America. That includes giving companies more financial incentives to develop antibiotics, giving the Food and Drug Administration more power to quickly approve and then limit the use of new antibiotics and making sure all hospitals, nursing homes and rehabilitation facilities follow best practices for using antibiotics, she says: «We want to make sure we use the right antibiotic in the right patient in the right dose at the right time.»
Some hospital systems and states require health care facilities to have formal antibiotic use plans, but most do not, Boucher says.
Patients and family members can do their part by asking about the medicines they are prescribed and questioning infection control in hospitals and other health care facilities, says Michael Bell, deputy director of CDC’s division of health care quality promotion. «If you are not comfortable asking questions, force yourself anyway … ask, ‘What are you doing to make sure my mom doesn’t get an antibiotic-resistant infection?’ «
The report also says limiting antibiotic use in animals raised for food is important. But it does not contain enough specific advice for those who might reduce that threat, including veterinarians, the food industry and the FDA, says Caroline Smith DeWaal, of the Center for Science in the Public Interest in Washington.
«For every antibiotic prescribed to a human, about three antibiotics are used in animals,» DeWaal says. She notes that the equation does not include antibiotics only used in animals. «If animals are fed too many antibiotics, it can end up in our food, it can end up in our water and it can end up in our environment.»
The CDC is working with the FDA and U.S. Department of Agriculture on food and animal-borne threats and has contributed to training programs for veterinarians, the report says. In 2012, the FDA asked food producers to stop putting antibiotics in animal feed to promote growth, but the guidelines do not have the force of law.

